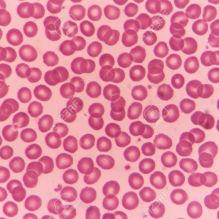
Normal red blood cells

BLOG October 2020
「あなたは、わたしの内臓を造り、母の胎内にわたしを組み立ててくださった。」(詩編139:13新改訳2017,2018)
この聖句を読んだ時、高校教師をしていたときに、一般生物学ではなく人体解剖学及び生理学を教えるよう依頼されたことを思い出した。生物学の一般的な知識から、人体に関してより具体的に詳細なものへと、自分の教授方法を変えなくてはならないと思ったが、この挑戦を引き受けることにした。最初の難題は、内臓を形成する組織を学ぶ組織学だった。骨についている筋肉によって、身体の動作が可能になるということを教えればいいだけではなく、骨格筋組織の構造がどのように動作を可能にするのかを教えることになる。人体の内側の組織を教えるために、私も知識を掘り下げる必要があった。まず様々な組織のプレパラートを顕微鏡で調べることを始めた。箱から骨格筋組織のプレパラートを取り出し、顕微鏡のステージの上に置き、低倍率に合わせた。そして少し倍率を上げ、さらに高倍率にした。その骨格筋を内部に向かって見ていくうちに、私は魅了されてしまった!さまざまな種類の組織のスライドを調べ続けて、それらのスライドから、各臓器がどのように働くのかを解き明かす、構造的パターンを発見したのだ。

なぜ骨格筋組織は、ロープに似た繊維の束のように見えるのだろう?筋肉は、腱で骨とくっついている。筋肉の伸縮が骨の動きにつながり、特定の動きをすることが出来るのだ。例えば、リンゴを噛むとき、筋肉は下顎を動かして、口を開けたり閉めたりする。あなたの顎にロープがくっついていて、そのロープが上下に動くと、顎が同じ動きをするのが思い浮かぶであろうか?
なぜ、血液組織の40%を構成する赤血球が、柔軟性のある卵型の円盤のような形をしているのだろう?赤血球細胞には、ヘモグロビンのためのスペースを最大にするために、核がない。赤血球はヘモグロビンの袋であり、酸素を運搬し身体のすみずみの組織に届ける。柔軟性があるために、血液は動脈や毛細血管床を通って移動することができる。もし、赤血球が長方形をしていて、硬かったらどうだろう?

なぜ緻密質(骨の表面を構成する組織)は、同心円状に配置されているのだろう?この並び方は、緻密質の組織を高密度にし、骨を保護し強度をあたえる。もしあなたの骨が一層、二層だけの骨組織により構成されていたとしたら、あなたの生活はどう違っただろうか?自然の中で、どこにこの同じパターンを見ることができるだろう?木の年輪? Tree limbsという言葉は、「大きな木の枝」という意味で、人体の「腕と脚」は、limbs(四肢)である。

そして最後に、なぜ神経組織は、神経細胞の塊のようなクモの巣状のもので構成され、長く繊維状に伸びて互いに接続されているのだろう? 神経組織は脳との間で情報をやり取りしている。神経細胞から情報を伝達する繊維は、軸索と言う。一番長い軸索は人体のどこにあるのだろう?坐骨神経の神経細胞の中にあり、それは、脊髄の基部からそれぞれの足の親指まで伸びている。
これらは人間の身体を形成する、多くの種類の組織のうちのわずか四つにすぎない。30兆個を超える細胞が互いに組み込まれて組織を形成し、組織が臓器を形成し、臓器が臓器系を形成し、最終的にはあなたになる。その創造的なパターンの不思議さを、感じてもらえるよう願う。
「あなたこそ 私の内臓を造り 母の胎の内で私を組み立てられた方です。」
「私は感謝します。あなたは私に奇(くす)しいことをなさって 恐ろしいほどです。私のたましいは それをよく知っています。」(詩編139:13-14新改訳2017,2018)